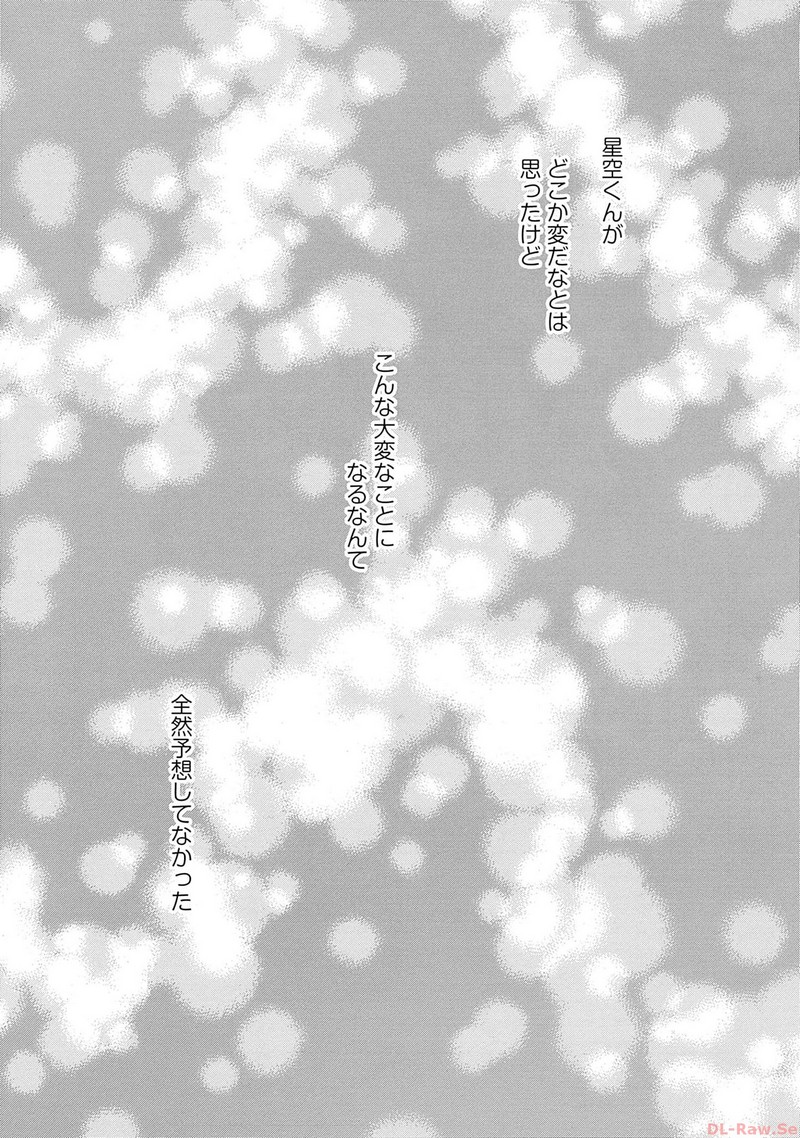
P9

P1 読込エラー
https://j4.rawxz.xyz/343F1F4-20636/512CE5B/1.jpg

P2 読込エラー
https://j4.rawxz.xyz/343F1F4-20636/512CE5B/2.jpg

P3 読込エラー
https://j4.rawxz.xyz/343F1F4-20636/512CE5B/3.jpg

P4 読込エラー
https://j4.rawxz.xyz/343F1F4-20636/512CE5B/4.jpg

P5 読込エラー
https://j4.rawxz.xyz/343F1F4-20636/512CE5B/5.jpg

P6 読込エラー
https://j4.rawxz.xyz/343F1F4-20636/512CE5B/6.jpg

P7 読込エラー
https://j4.rawxz.xyz/343F1F4-20636/512CE5B/7.jpg

P8 読込エラー
https://j4.rawxz.xyz/343F1F4-20636/512CE5B/8.jpg

P9 読込エラー
https://j4.rawxz.xyz/343F1F4-20636/512CE5B/9.jpg

P10 読込エラー
https://j4.rawxz.xyz/343F1F4-20636/512CE5B/10.jpg

P11 読込エラー
https://j4.rawxz.xyz/343F1F4-20636/512CE5B/11.jpg

P12 読込エラー
https://j4.rawxz.xyz/343F1F4-20636/512CE5B/12.jpg

P13 読込エラー
https://j4.rawxz.xyz/343F1F4-20636/512CE5B/13.jpg

P14 読込エラー
https://j4.rawxz.xyz/343F1F4-20636/512CE5B/14.jpg

P15 読込エラー
https://j4.rawxz.xyz/343F1F4-20636/512CE5B/15.jpg

P16 読込エラー
https://j4.rawxz.xyz/343F1F4-20636/512CE5B/16.jpg

P17 読込エラー
https://j4.rawxz.xyz/343F1F4-20636/512CE5B/17.jpg

P18 読込エラー
https://j4.rawxz.xyz/343F1F4-20636/512CE5B/18.jpg

P19 読込エラー
https://j4.rawxz.xyz/343F1F4-20636/512CE5B/19.jpg

P20 読込エラー
https://j4.rawxz.xyz/343F1F4-20636/512CE5B/20.jpg

P21 読込エラー
https://j4.rawxz.xyz/343F1F4-20636/512CE5B/21.jpg

P22 読込エラー
https://j4.rawxz.xyz/343F1F4-20636/512CE5B/22.jpg

P23 読込エラー
https://j4.rawxz.xyz/343F1F4-20636/512CE5B/23.jpg

P24 読込エラー
https://j4.rawxz.xyz/343F1F4-20636/512CE5B/24.jpg

P25 読込エラー
https://j4.rawxz.xyz/343F1F4-20636/512CE5B/25.jpg

P26 読込エラー
https://j4.rawxz.xyz/343F1F4-20636/512CE5B/26.jpg

P27 読込エラー
https://rawxz.lat/wp-content/uploads/2017/10/xzzz1.png

P28 読込エラー
http://rawzo.net/wp-content/uploads/2026/04/raw-manga.jpg

P29 読込エラー
http://rawzo.net/wp-content/uploads/2026/04/raw-manga.jpg

P30 読込エラー
http://rawzo.net/wp-content/uploads/2026/04/raw-manga.jpg

P31 読込エラー
http://rawzo.net/wp-content/uploads/2026/04/raw-manga.jpg

P32 読込エラー
https://rawxz.site/wp-content/themes/manga-theme-MangaVerse/img-proxy.php?url=http%3A%2F%2Frawzo.net%2Fwp-content%2Fuploads%2F2026%2F04%2Fraw-manga.jpg

P33 読込エラー
https://rawxz.site/wp-content/themes/manga-theme-MangaVerse/img-proxy.php?url=http%3A%2F%2Frawzo.net%2Fwp-content%2Fuploads%2F2026%2F04%2Fraw-manga.jpg

P34 読込エラー
https://rawxz.lat/wp-content/uploads/2026/03/65972-75x106.jpg

P35 読込エラー
https://rawxz.lat/wp-content/uploads/2026/03/41165-75x106.jpg

P36 読込エラー
https://rawxz.lat/wp-content/uploads/2026/03/62577-75x106.jpg

P37 読込エラー
https://rawxz.lat/wp-content/uploads/2026/03/39669-75x106.jpg

コメント 0
まだコメントがありません。最初のコメントを書いてみましょう!